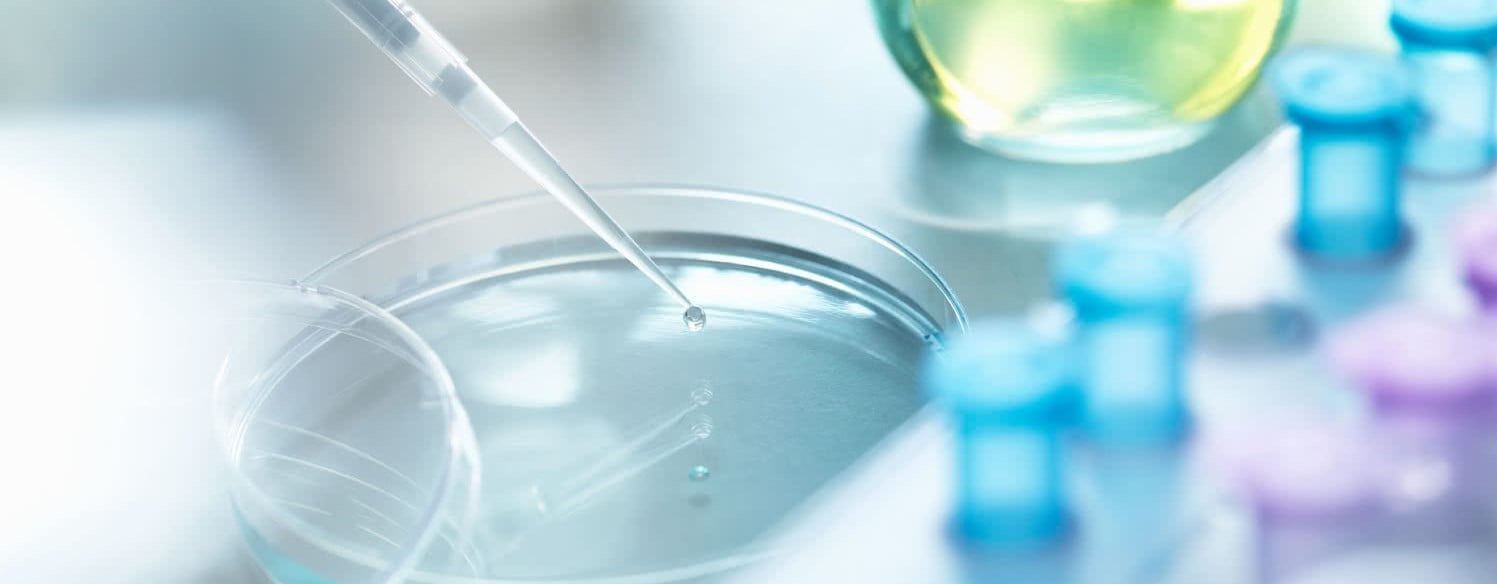

We are the pioneers of test-based, personalized nutrition
From the land of the northern lights, midnight sun, deepest fjords and steepest mountains.
We are the pioneers of test-based, personalized nutrition
From the land of the northern lights, midnight sun, deepest fjords and steepest mountains.
OUR TEST-BASED NUTRITION STRATEGY
Your journey starts with our health tests. That’s how we bring you and the world back into balance


Step out of the dark. Join the new standard for personal health
Backed by our Scientific Advisory Board and our in-house R&D specialists
OUR BLOOD SPOT TESTS
Knowledge is power. Your journey to awareness begins with one drop of blood
OUR BLOOD SPOT TESTS
Knowledge is power. Your journey to awareness begins with one drop of blood
Our dried blood spot test gives you the hard facts on the current state of your health.

Vitas is the world leader in blood spot testing, a GMP-certified chemical analysis contract lab.

1,581,120 BalanceTests performed to date
OUR BALANCE CONCEPT
Our formula is a true force of nature.
And olive oil is the game-changer
That’s why our BalanceOil+ is closer to oily fish than fish oil.
That’s why our BalanceOil+ is closer to oily fish than fish oil.
OUR BALANCE CONCEPT
Backed by science.
Powered by nature
OUR BALANCE CONCEPT
Backed by science.
Powered by nature
OUR TESTS & SUPPLEMENTS
The tests reveal unique insights. Our supplements manage every part of it
One small BalanceShot.
A quantum leap for human health
One small BalanceShot.
A quantum leap for human health
Start subscribing to a better life
Your health is not a quick fix. A subscription gives our supplements time to do their job. Home deliveries every other month give our planet a break.

Our Partners are with you all the way
A personal wellness consultant is always part of your subscription. We will monitor your progress and keep you on track until you reach your health goals.











Share this page
Or copy link